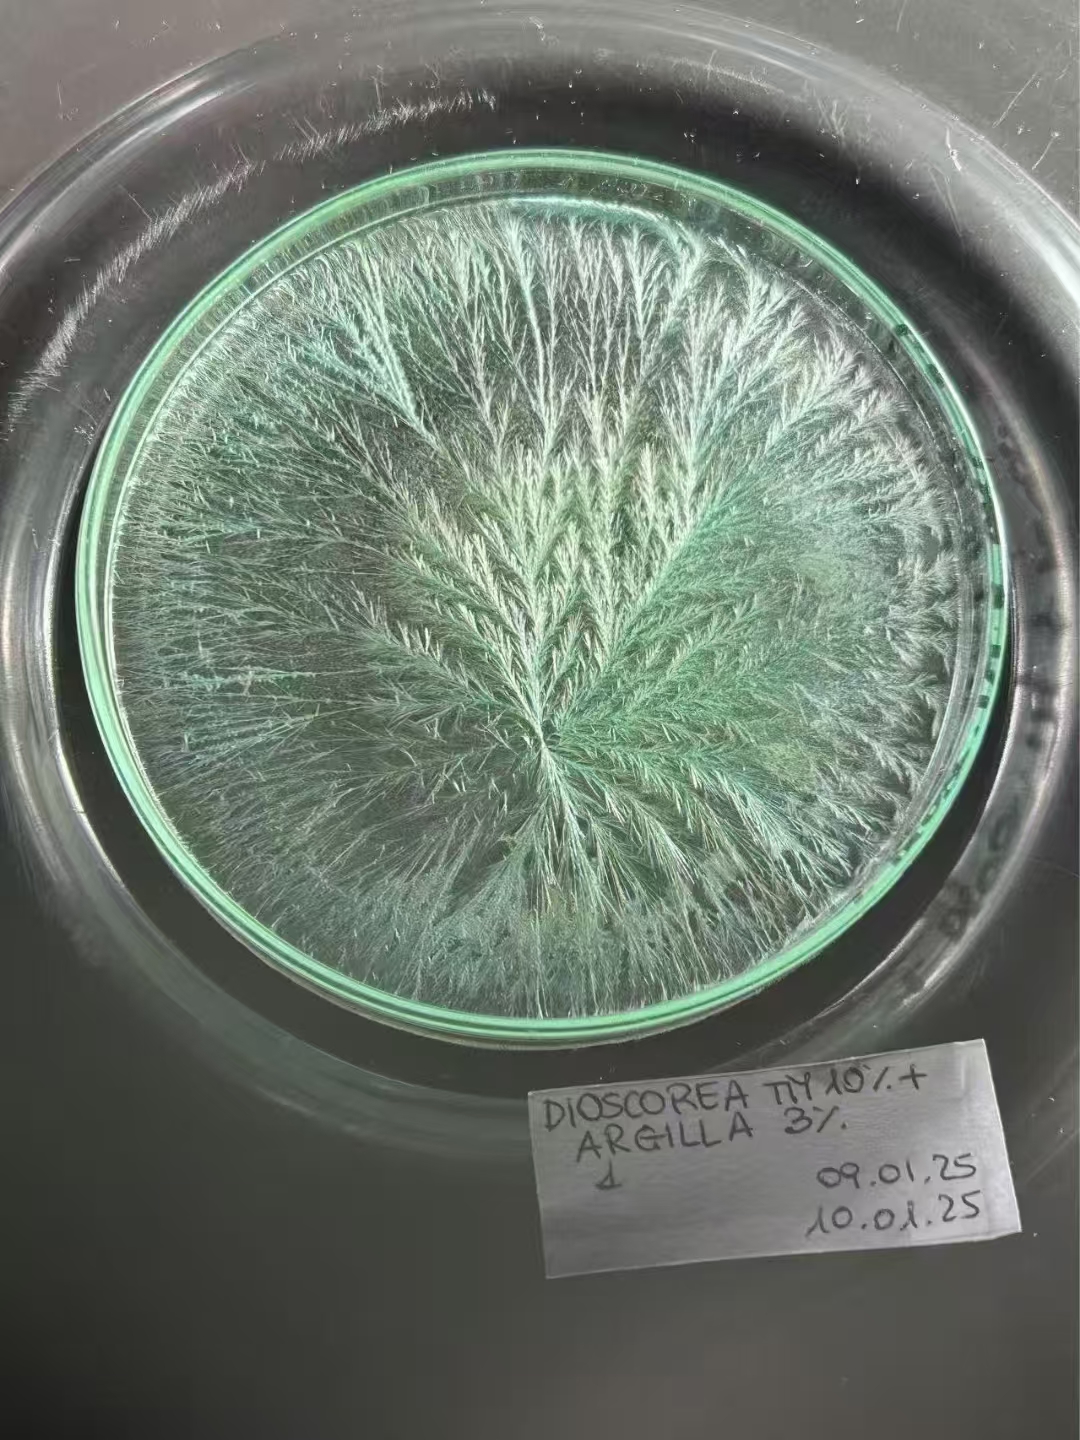

雅琪朵玫瑰洗面奶/洁面乳 | 公平贸易*Rose Petal Cleanser| Fair Trade Items
| 运费: | ¥ 0.00-17.00 |
| 库存: | 347 件 |
商品详情
雅琪朵玫瑰洗面奶/洁面乳
Rose Petal Cleanser
成分:水、月桂酰两性基乙酸钠、乙醇、漂白士、乳酸、椰油酰水解小麦蛋白钠、黄原胶、母菊(CHAMOMILLA RECUTITA)花提取物、肌醇六磷酸、安息香(STYRAXBENZOIN)树脂提取物;其他微量成分:杂薰衣草(LAVANDULA HYBRIDA)油、突厥蔷薇(ROSADAMASCENA)花提取物、香叶醇、欧洲小檗(BERBERIS VULGARIS)根提取物、香茅醇、苯乙醇、香叶天竺葵(PELARGONIUM GRAVEOLENS)花油、2,6-二甲基-7-辛烯-2-醇、突厥蔷薇(ROSA DAMASCENA)花油。
(注:“玫瑰”指产品中“突厥蔷薇(ROSA D-AMASCENA)花油”成分。原包装中“greenClay绿泥”指产品中“漂白土”成分。)
净含量:125ml/瓶、250ml/瓶;
备案人/生产企业名称及地址:雅琪朵费拉萝公司/莫迪卡市科技大街9(邮编97015)
产地:意大利原装进口
认证:意大利 ICEA 有机认证
适合肤质:所有肤质,包含敏敏肌肤
功效:提亮肤色 深层清洁 清洁毛孔
使用方法:摇晃均匀后,在湿润的手心滴3-5滴洗面奶轻轻揉搓起泡,再上脸按摩1-2分钟,用温水冲洗干净即可。
保质期:3年,开封后4个月使用完。
贮存条件:阴凉干燥处存放,避免阳光直射。
退货说明:为了保证各位用户的权益,如需退货,必须在无使用过,并不影响二次销售的提前下申请退款,如不是质量问题的退货,退回运费需要自理。
发货方式:该产品从意大利原装进口,下单后从福建仓顺丰发出,下单后1-2天内发货。不参与广东省内满300包邮活动。受天气或库存等原因影响可能偶有耽误,急单请发货前咨询客服,不接受没有提前沟通的拒收。
有机养肤洁面,水润不紧绷

用天然来源的增稠剂黄原胶,将植物起泡剂、绿泥、植物提取物和精油成分融合,实现温和+清洁力并存,不伤皮肤自有保护膜,呈现绿色乳液质感。

成分特点

月桂酰两性基乙酸钠
原料来源于椰子油,产生的泡沫细腻,对皮肤和眼睛的刺激性较低,并有一定保湿效果,在清洁时有助于保持皮肤水分。
椰油酰水解小麦蛋白钠
是源自椰子油与水解小麦蛋白通过天然化学反应而合成的一种泡沫剂和辅助乳化剂。具有温和清洁,舒缓皮肤,增加皮肤光泽度。
绿泥
绿天然的矿物质,可以提升洗面奶的清洁力,可以深入毛孔清洁油脂,预防毛孔堵塞,减少黑头、粉刺。
德国洋甘菊、大马士革玫瑰、千叶玫瑰
提升洁面后皮肤白皙、柔软和光滑感。同时替代人工香精,给予洗面奶天然精油的香气。
安息香树脂提取物、刺檗萃取物
天然防腐剂
黄原胶
天然来源的增稠剂,通过微生物(野油菜黄单胞菌)发酵植物源糖类制成(如:小麦、卷心菜、花椰菜等植物)。





品牌起源

ARGITAL意大利有机品牌创立于1979年,致力于发展有机绿泥和植物精油对改善人体身心平衡的产品。

费拉罗博士是雅琪朵品牌的创立者,也是一位生物学家。他深入研究中医学、印度医学和鲁道夫斯坦纳的人智学,从而创造出以绿泥和有机植物为主要原料的护理产品。

发现核心成分绿泥

费拉罗从小在西西里岛长大,13岁的他在海边玩耍的时候不小心受伤,意外发现海边土丘上沾着的绿泥可以促进伤口愈合,而且细心的他还发现绿泥还使伤口周围的肌肤更加白净嫩滑。

创始人:费拉罗博士
位于西西里岛最南端,那里全年日照充足通风良好,自然绿泥矿,历经1600万年岁月的沉淀,富含矿物质和天然微量元素。雅琪朵自有的矿场,每年夏天挖出,经过太阳晾晒风干,用于护理产品中,帮助清洁,促进细胞更新,抵抗衰老。



有机植物

意大利ICEA规范下的有机种植,完全遵从植物生长的自然规律,种植过程,不使用化肥农药,生长调节剂、转基因技术等,未经污染的土壤种植。从而保证雅琪朵产品原料的品质。

ICEA认证禁止使用化学成分,有明确的禁用物质清单,并会定期审核及抽查产品,如有不符合立即取消认证标章。ICEA的认证增加了公司品牌和产品的价值。

零残忍认证组织是No animal testing(无动物实验)和No animal ingredients(无动物成分)产品认证的机构。自成立以来,国际零残忍组织每天都在争取人类对动物生存权利的肯定,反对人类对动物进行任何形式的剥削。
GOLD精油制备专利

雅琪朵所有的产品都含有精油,GOLD精油的生产方法是ARGITAL独有的,它能唤起整株植物的能量,包括花、椰和根,以获得其原始的香气,一种柔和、丰富且均衡的香气,可用作于皮肤和心灵。

17.5 2024年拍摄
敏感结晶:
验证绿泥和植物的活性(水和氯化铜)

17.6 2024年拍摄
敏感结晶:
验证绿泥凝胶和薄荷精油的活性
17.9 2025年拍摄
敏感结晶:
验证山药提取物活性
卡拉布里亚活泉水

水常看不起眼,其实是洗护用品所占比重非常多的,雅琪朵产品用卡拉布里亚天然的活泉水,特殊的地理环境赋予其纯净、安全、健康。天然的小分子水更容易通过表层肌肤来激发肌肤活性,增强肌肤的吸收能力。

雅琪朵洗涤产生的水不会对环境有污染,这是对人类和环境的尊重。
自主实验室研发,自有工厂生产

雅琪朵从1984年以来相继获得了德米特、德国BDIH、意大利ICEA等七大认证,而维护动物生存权力协会认证,就是不在动物身上做试验,不使用动物的衍生品。产品自主实验室研发,自有工厂来生产,品质把控和安全有保障。

雅琪朵每款产品至少都获得一个外国的有机认证,不同的产品获得的外国有机认证也不一样,甚至一款产品是多个外国的有机认证。

蜂窝牛皮纸和拉菲草作为缓冲物,更环保的发货包装方式,减少塑料的使用。

- 绿手指有机农园 (微信公众号认证)
- 通过购买行为,抵制不安全的食物生产链,了解您的食物生产者,选择有温度有诚意的食物,支持青年返乡,保护乡村土壤。
- 扫描二维码,访问我们的微信店铺
- 随时随地的购物、客服咨询、查询订单和物流...





